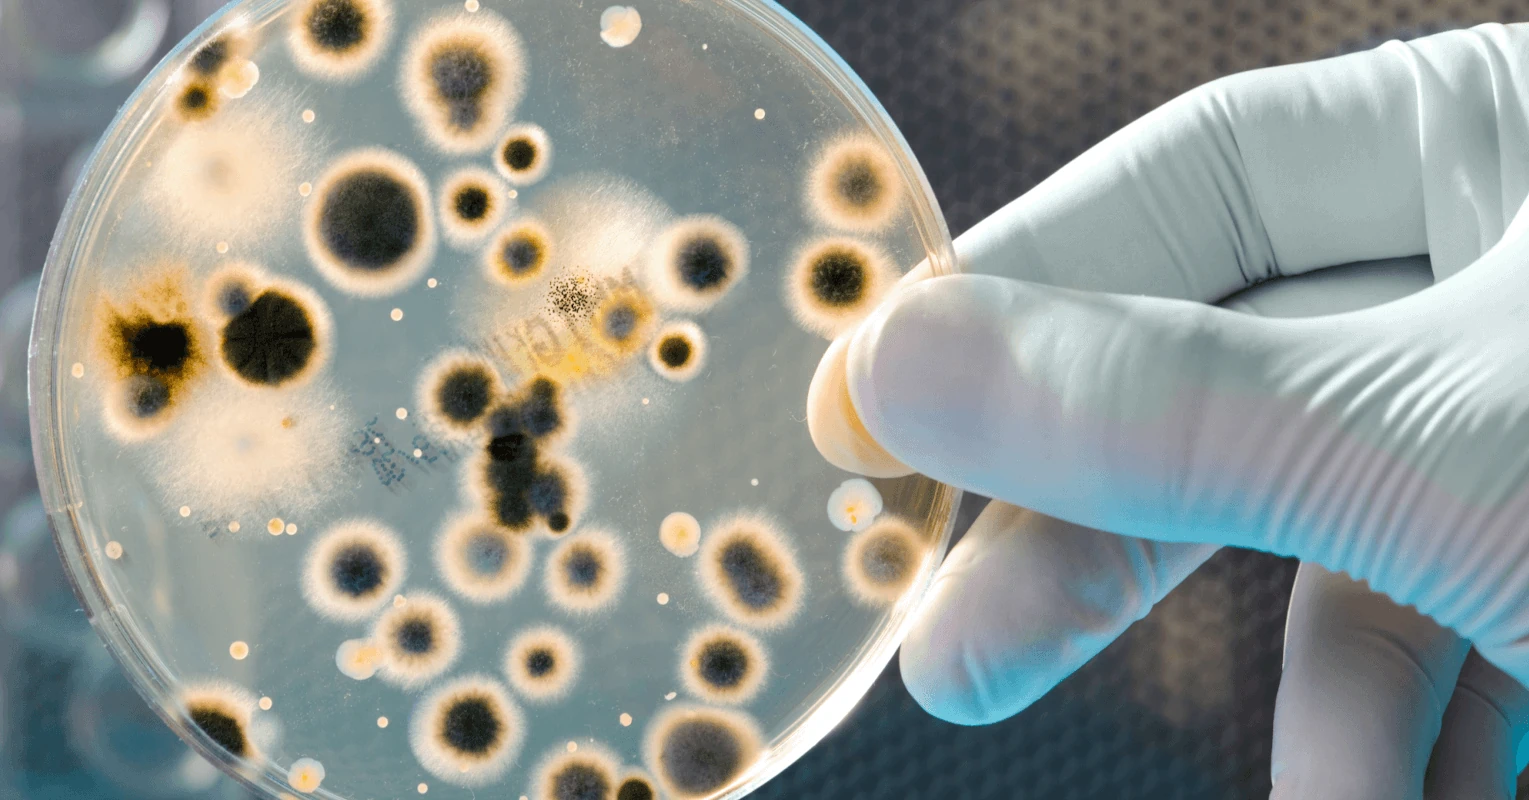
La diversità microbica aiuta gli astronauti a mantenere un sistema immunitario sano nello spazio. Scopri i risultati della nuova ricerca

Gli astronauti che vivono per lunghi periodi in ambienti isolati e altamente sterilizzati, come la Stazione Spaziale Internazionale (ISS), potrebbero mantenere una migliore salute esponendosi a una maggiore varietà di microbi terrestri. Una nuova ricerca pubblicata sulla rivista Cell (rif.) suggerisce che l’introduzione controllata di comunità microbiche potrebbe rafforzare il sistema immunitario degli astronauti senza compromettere le condizioni igieniche. “Gli ambienti sterili non sono, in realtà, i più sicuri”, ha affermato Rob Knight, professore presso l’Università della California, San Diego, e coautore dello studio. “L’esposizione alla diversità microbica è fondamentale per mantenere la salute, poiché, in quanto esseri umani, ci siamo co-evoluti con questi microrganismi ambientali per milioni di anni”.
Lo stress della microgravità e la risposta immunitaria
Gli astronauti della ISS affrontano numerosi fattori di stress che influenzano il loro organismo. L’esposizione alla microgravità e alle radiazioni altera la risposta immunitaria, rendendo più difficile per il corpo combattere le infezioni rispetto a quanto avviene sulla Terra. Studi precedenti della NASA hanno evidenziato come alcuni disturbi medici persistenti, tra cui eruzioni cutanee, herpes labiale e allergie atipiche, possano essere correlati alle modificazioni del sistema immunitario nello spazio.
La nuova ricerca, condotta dal team di Knight, suggerisce che un’adeguata diversità microbica potrebbe migliorare la salute generale degli astronauti. L’introduzione controllata di microrganismi provenienti dal suolo e dall’acqua terrestri potrebbe offrire un supporto essenziale alla funzione immunitaria senza compromettere la sanitizzazione della stazione spaziale. L’analisi si basa su 803 campioni prelevati da superfici della sezione statunitense della ISS, fornendo il più ampio dataset mai realizzato sulla composizione microbica e chimica della stazione.
I risultati mostrano che la distribuzione dei microbi è strettamente legata all’ambiente in cui si trovano. Microrganismi legati agli alimenti sono più abbondanti nelle aree di stoccaggio e consumo dei cibi, mentre quelli di origine fecale predominano nel compartimento dedicato all’igiene e ai rifiuti. Confrontando questi campioni con migliaia di altri raccolti sulla Terra, i ricercatori hanno riscontrato che la ISS presenta una forte presenza di sostanze chimiche derivate da prodotti per la pulizia e disinfettanti, simili a quelle rilevate in ospedali e ambienti urbani altamente sterilizzati. Questa ridotta diversità microbica potrebbe rendere l’ambiente della ISS meno ottimale nel supportare le funzioni immunitarie degli astronauti.
Verso il futuro delle missioni spaziali
“Ci auguriamo che questo studio possa guidare ricerche future volte a mantenere in salute gli astronauti durante le missioni spaziali a lungo termine e nella colonizzazione dello spazio”, ha dichiarato Knight. Tuttavia, prima di introdurre nuovi microbi nell’ambiente della ISS, gli scienziati devono valutare il rischio che microrganismi normalmente innocui sulla Terra possano diventare dannosi nello spazio.
Questo pericolo potrebbe derivare dalla riduzione della diversità microbica o dall’aumento delle mutazioni dovute all’esposizione alle radiazioni. “Questi fattori possono essere testati sulla Terra prima di procedere con costosi esperimenti nello spazio”, ha concluso Knight.
- Le onde gravitazionali e il battito dell’universo primordiale - 24 Ottobre 2025
- I colori nascosti della materia oscura - 22 Ottobre 2025
- Un raro evento di distruzione mareale - 20 Ottobre 2025